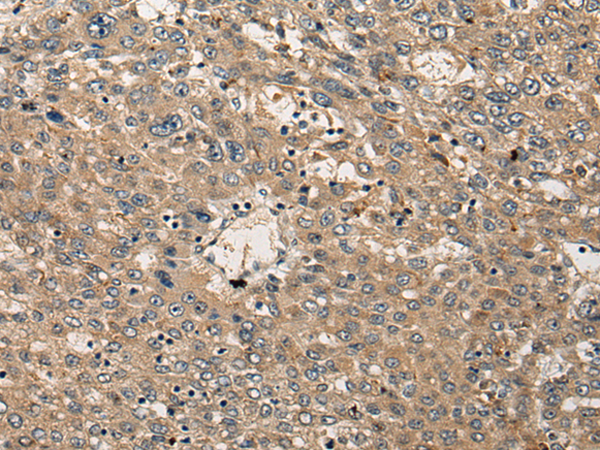

-
分类: 科研抗体货号: P13025别名: ETO2; MTG16; MTGR2; ZMYND4; RUNX1T3应用: IHC反应种属: Human, Mouse
-
分类: 科研抗体货号: P13023别名: CBF; CBF2; NOC1; HSP-CBF应用: WB,IHC反应种属: Human
-
分类: 科研抗体货号: P13022别名: CATSF; CLN13应用: IHC反应种属: Human, Mouse
-
分类: 科研抗体货号: P13039别名: B7H3; B7-H3; B7RP-2; 4Ig-B7-H3应用: WB,IHC反应种属: Human, Mouse, Rat
-
分类: 科研抗体货号: P13059别名: ELA1应用: IHC反应种属: Human, Mouse, Rat
-
分类: 科研抗体货号: P13052别名:应用: WB,IHC反应种属: Human, Mouse
-
分类: 科研抗体货号: P13038别名: R1; CD1; CD1A应用: IHC反应种属: Human
-
分类: 科研抗体货号: P13058别名: CED6; GULP; CED-6应用: IHC反应种属: Human, Mouse, Rat
-
分类: 科研抗体货号: P13051别名: P56; KKIAMRE应用: WB,IHC反应种属: Human, Mouse, Rat
-
分类: 科研抗体货号: P13037别名: CD153; CD30L; CD30LG; TNLG3A应用: IHC反应种属: Human

鄂公网安备42018502007531号
鄂公网安备42018502007531号

